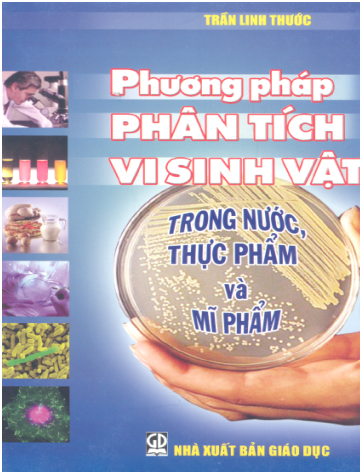
Phương Pháp Phân Tích Vi Sinh Vật (NXB Giáo Dục 2006) - Trần Linh Thước, 233 Trang

Giao Tiếp Sinh Học Ở Động Vật (NXB Giáo Dục 2009) - Bùi Công Hiển, 177 Trang
Thể loại: Chuyên Ngành Sinh Học
Sách ebook được sưu tầm từ Internet, Bản quyền sách thuộc về Tác giả & Nhà xuất bản. Nếu có điều kiện bạn hãy mua sách ủng hộ tác giả.
Tải sách Giao Tiếp Sinh Học Ở Động Vật (NXB Giáo Dục 2009) - Bùi Công Hiển, 177 Trang pdf miễn phí
trong đời sống xã hội, có biết bao câu chuyện chỉ vì hiểu lầm nhau mà kết thúc thật thương tâm. còn trong đời sống với thiên nhiên, với sinh vật, không thể kể hết những câu chuyện "thương nhau như thế bằng mười phụ nhat", tức là chúng ta chăm sóc sinh vật, chăm sóc thiên nhiên theo cách hiểu chủ quan của mình, mà không lắng nghe "nguyện vọng chính đáng" của sinh vật.
cuối năm 2005, cố viện sĩ vũ tuyên hoàng với tư cách chủ tịch hội các ngành sinh học việt nam đã chủ trì cuộc hội thảo chuyên đề khoa học về giao tiếp sinh học. hội thảo này đã được nhiều giáo sư, các chuyên gia sinh học tham gia và cho rằng, chúng ta đã tiếp cận hơi muộn về lĩnh vực này so với thế giới.
trong vài năm gần đây, tác giả được khoa sinh học, trường Đại học khoa học tự nhiên, Đại học quốc gia hà nội giao nhiệm vụ giảng dạy chuyên đề "giao tiếp sinh học ở động vật" cho học viên cao học. Đặc biệt, năm 2008, ban giám hiệu trường Đại học khoa học tự nhiên, Đại học quốc gia hà nội đã giao nhiệm vụ, tạo điều kiện về vật chất và tinh thần cho tác giả hoàn thành tài liệu này và được coi như một trong những tài liệu tham khảo chính, làm cơ sở khoa học để hiểu biết tập tính động vật.
- giao tiếp sinh học Ở Động vật
- nxb giáo dục 2009
- bùi công hiển
- 177 trang
- file pdf-ocr